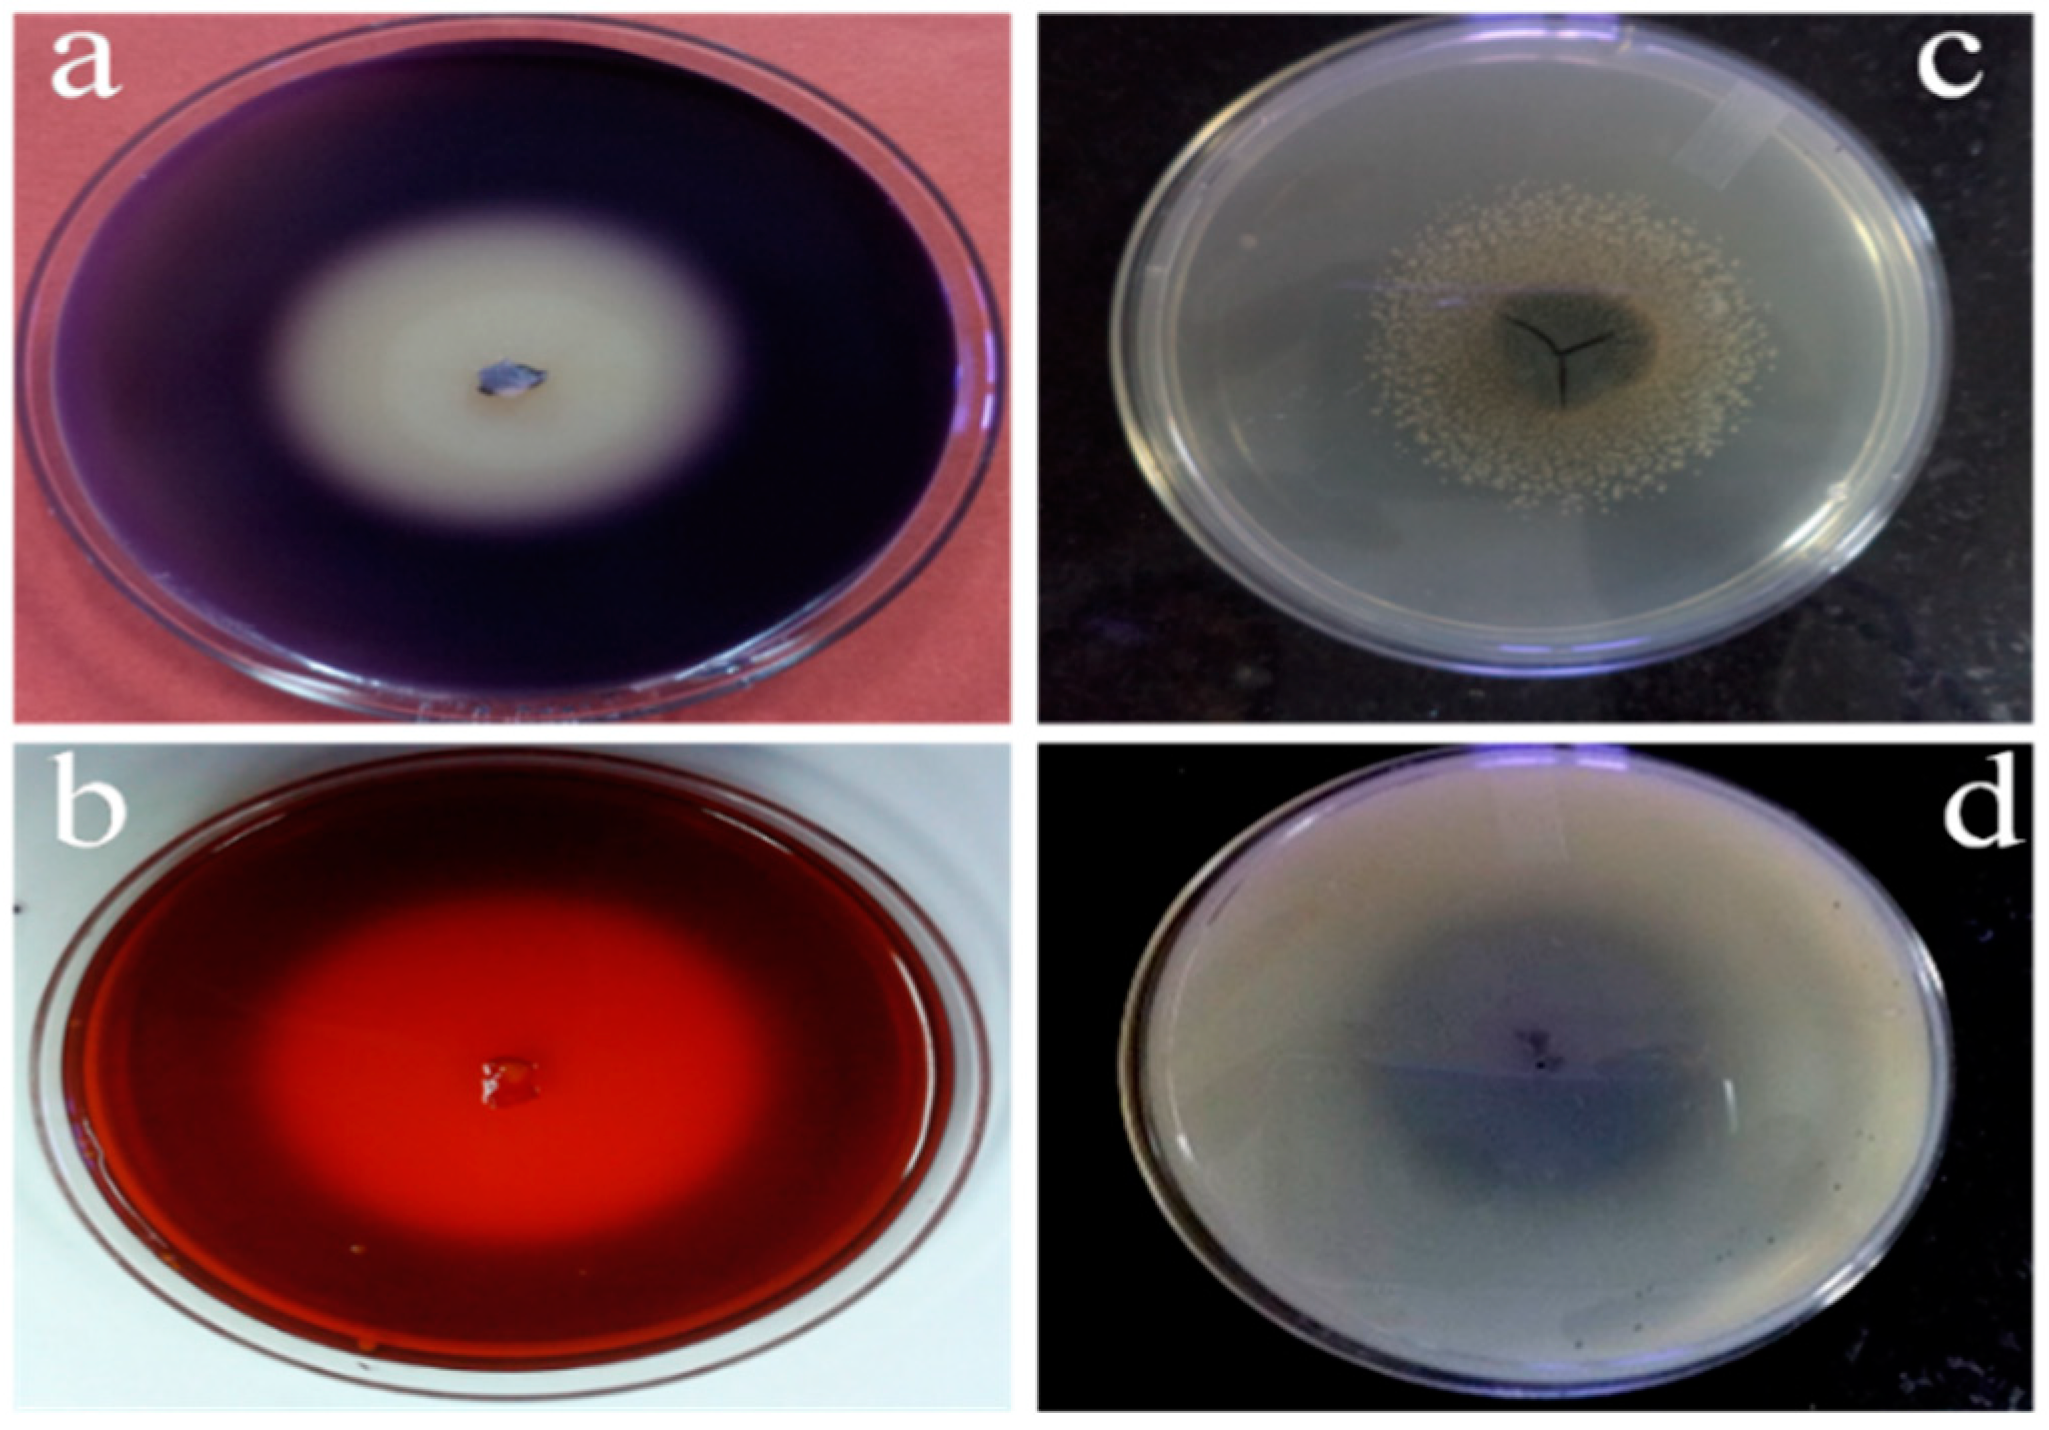
Sustainability 14 14814 g005

Identification of Fungal Communities Isolated from Himalayan Glacier Cryoconites
Abstract
1. Introduction
2. Materials and Methods
2.1. Cryoconite Sample Collection and Isolation of Fungi
2.2. DNA Extraction, PCR, Sequencing, and Phylogenetic Analysis
2.3. Physiological Characterization
2.4. Carbohydrate Assimilation Test
2.5. Antibiotic Susceptibility Test
2.6. Screening of Enzymes
3. Results
3.1. Isolation of Culturable Fungi
3.2. Phylogenetic Analysis
3.3. Growth Temperature, pH, and Salt Tolerance of Fungal Isolates
3.4. Carbohydrate Utilization of Fungal Isolates
3.5. Antibiotic Resistance and Sensitivity Patterns of the Isolated Strains
3.6. Extracellular Enzyme Activities
4. Discussion
5. Conclusions
Supplementary Materials
Author Contributions
Funding
Institutional Review Board Statement
Informed Consent Statement
Data Availability Statement
Acknowledgments
Conflicts of Interest
References
- Stibal, M.; Sabacka, M.; Zarsky, J. Biological processes on glacier and ice sheet surfaces. Nat. Geosci. 2012, 5, 771–774. [Google Scholar] [CrossRef]
- Kulkarni, A.V.; Karyakarte, Y. Observed changes in Himalayan glaciers. Curr. Sci. 2014, 106, 237–244. [Google Scholar]
- Takeuchi, N.; Kohshima, S.; Seko, K. Structure, formation, and darkening process of albedo-reducing material (cryoconite) on a Himalayan glacier: A granular algal mat growing on the glacier. Arct. Antarct. Alp. Res. 2001, 33, 115–122. [Google Scholar] [CrossRef]
- Singh, S.M.; Avinash, K.; Sharma, P.; Mulik, R.U.; Upadhyay, A.K.; Ravindra, R. Elemental variations in glacier cryoconites of Indian Himalaya and Spitsbergen, Arctic. Geosci. Front. 2017, 8, 1339–1347. [Google Scholar] [CrossRef]
- Takeuchi, N.; Matsuda, Y.; Sakai, A.; Fujita, K. A large amount of biogenic surface dust (cryoconite) on a glacier in the Qilian Mountains, China. Bull. Glaciolog. Res. 2005, 22, 1–8. [Google Scholar]
- Kastovska, K.; Elster, J.; Stibal, M.; Santruckova, H. Microbial assemblages in soil microbial succession after glacial retreat in Svalbard (High Arctic). Microb. Ecol. 2005, 50, 396–407. [Google Scholar] [CrossRef]
- Singh, P.; Singh, S.M. Characterization of yeast and filamentous fungi isolated from cryoconite holes of Svalbard, Arctic. Polar Biol. 2012, 35, 575–583. [Google Scholar] [CrossRef]
- Christner, B.C.; Krivko, I.B.H.; Reeve, J.N. Molecular identification of bacteria and eukarya inhabiting an Antarctic cryoconite hole. Extremophiles 2003, 7, 177–183. [Google Scholar] [CrossRef]
- Margesin, R.; Zacker, G.; Schinner, F. Characterization of heterotrophic microorganisms in alpine glacier cryoconite. Arct. Antarct. Alp. Res. 2002, 34, 88–93. [Google Scholar] [CrossRef]
- Vincent, W.F. Cold Tolerance in Cyanobacteria and Life in the Cryosphere. In Algae and Cyanobacteria in Extreme Environments; Seckbach, J., Ed.; Springer: Berlin/Heidelberg, Germany, 2007; pp. 287–301. [Google Scholar]
- Singh, P.; Singh, S.M.; Dhakephalkar, P. Diversity, cold active enzymes and adaptation strategies of bacteria inhabiting glacier cryoconite holes of High Arctic. Extremophiles 2014, 18, 229–242. [Google Scholar] [CrossRef]
- Singh, P.; Roy, U.; Tsuji, M. Characterization of yeast and filamentous fungi from Broggerbreen glaciers, Svalbard. Polar Rec. 2016, 52, 442–449. [Google Scholar] [CrossRef]
- Russell, N.; Fukunaga, N. A comparison of thermal adaptation of membrane lipids in psychrophilic and thermophilic bacteria. FEMS Microbiol. Lett. 1990, 75, 171–182. [Google Scholar] [CrossRef]
- Margesin, R.; Dieplinger, H.; Hofmann, J.; Sarg, B.; Lindner, H. A coldactive extracellular metalloprotease from Pedobactercryoconitis-production and properties. Res. Microbiol. 2005, 156, 499–505. [Google Scholar] [CrossRef] [PubMed]
- Bej, A.K.; Mojib, N. Cold Adaptation in Antarctic Biodegradative Microorganisms. In Polar Microbiology: The Ecology, Biodiversity and Bioremediation Potential of Microorganisms in Extremely Cold Environments; Bej, A.K., Aislabie, J., Atlas, R.M., Eds.; CRC Press: Boca Raton, FL, USA, 2010. [Google Scholar]
- Chaturvedi, P.; Prabahar, V.; Manorama, R.; Pindi, P.K.; Bhadra, B.; Begum, Z.; Shivaji, S. Exiguobacterium soil sp. nov., a psychrophilic bacterium from the McMurdo Dry Valleys, Antarctica. Int. J. Syst. Evol. Microbiol. 2008, 58, 2447–2453. [Google Scholar] [CrossRef]
- Kishore, K.H.; Begum, Z.; Pathan, A.A.K.; Shivaji, S. Paenibacillus glacialis sp. nov., isolated from the Kafni glacier of the Himalayas, India. Int. J. Syst. Evol. Microbiol. 2010, 60, 1909–1913. [Google Scholar] [CrossRef]
- Bisht, S.C.; Mishra, P.K.; Joshi, G.K. Genetic and functional diversity among root associated psychrotrophic pseudomonas isolated from the Himalayan plants. Arch. Microbiol. 2013, 195, 605–615. [Google Scholar] [CrossRef]
- Geological Survey of India—GSI. Detailed glaciological studies on Hamtah Glacier, Lahaul and SpitidistrictHimachal Pradesh. Rec. Geol. Surv. India 2009, 139 Pt 8, 136–139. [Google Scholar]
- Veysseyre, A.; Moutard, K.; Ferrari, C.; van de Velde, K.; Barbante, C.; Cozzi, G.; Capodaglio, G.; Boutron, C. Heavy metals in fresh snow collected at different altitudes in the Chamonix and Maurienne valleys, French Alps: Initial results. Atmos. Environ. 2001, 35, 415–425. [Google Scholar] [CrossRef]
- Waksman, S.A. Do fungi live and produce mycelium in the soil? Science 1916, 44, 320–322. [Google Scholar] [CrossRef][Green Version]
- Kurtzman, C.P.; Fell, J.W.; Boekhout, T.; Robert, V. Methods for the isolation, phenotypic characterization and maintenance of Yeasts. In The Yeast, a Taxonomic Study; Kurtzman, C.P., Fell, J.W., Boekhout, T., Eds.; Elsevier: Amsterdam, The Netherlands, 2011; pp. 87–110. [Google Scholar]
- Katoh, K.; Standley, D.M. MAFFT multiple sequence alignment software version 7: Improvements in performance and usability. Mol. Biol. Evol. 2013, 30, 772–780. [Google Scholar] [CrossRef]
- Kumar, S.; Stecher, G.; Tamura, K. MEGA7: Molecular Evolutionary Genetics Analysis version 7.0 for bigger datasets. Mol. Biol. Evol. 2016, 33, 1870–1874. [Google Scholar] [CrossRef] [PubMed]
- Ronquist, F.; Teslenko, M.; van der Mark, P.; Ayres, D.L.; Darling, A.; Höhna, S.; Larget, B.; Liu, L.; Suchard, M.A.; Huelsenbeck, J.P. Efficient Bayesian phylogenetic inference and model choice across a large model space. Syst. Biol. 2012, 61, 539–542. [Google Scholar] [CrossRef] [PubMed]
- Bauer, A.W.; Kirby, M.; Sherris, J.C.; Truck, M. Antibiotic susceptibility testing by a standardized single disk method. Am. J. Clin. Pathol. 1966, 45, 493–496. [Google Scholar] [CrossRef] [PubMed]
- Gupta, P.; Samant, K.; Sahu, A. Isolation of cellulose-degrading bacteria and determination of their cellulolytic potential. Int. J. Microbiol. 2012, 2012, 578925. [Google Scholar] [CrossRef]
- Taylor, W.; Achanzar, D. Catalase test as an aid to the identification of Enterobacteriaceae. J. Appl. Microbiol. 1972, 24, 58–61. [Google Scholar] [CrossRef]
- Turchetti, B.; Buzzini, P.; Goretti, M.; Branda, E.; Diolaiuti, G.; D’Agata, C.; Smiraglia, C.; Vaughan-Martini, A. Psychrophilic yeasts in glacial environments of Alpine glaciers. FEMS Microbiol. Ecol. 2008, 63, 73–83. [Google Scholar] [CrossRef]
- Thomas-Hall, S.R.; Turchetti, B.; Buzzini, P.; Branda, E.; Boekhout, T.; Theelen, B.; Watson, K. Cold-adapted yeasts from Antarctica and the Italian Alps—Description of three novel species: Mrakiarobertii sp. nov., Mrakia blollopis sp. nov. and Mrakiella niccombsii sp. nov. Extremophiles 2009, 14, 47–59. [Google Scholar] [CrossRef]
- Carrasco, M.; Villarreal, P.; Barahona, S.; Alcaino, J. Screening and characterization of amylase and cellulase activities in psychrotolerant yeasts. BMC Microbiol. 2006, 16, 21. [Google Scholar] [CrossRef]
- Singh, P.; Tsuji, M.; Singh, S.M.; Roy, U.; Hoshino, U. Taxonomic characterization, adaptation strategies and biotechnological potential of cryophilic yeasts from ice cores of Midre Lovénbreen glacier, Svalbard, Arctic. Cryobiology 2013, 66, 167–175. [Google Scholar] [CrossRef]
- Gardner, P.; Smith, D.H.; Beer, H.; Moellering, R.C. Recovery of resistance (R) factors from a drug-free community. Lancet 1969, 2, 774–776. [Google Scholar] [CrossRef]
- Martinez, J.L. Natural antibiotic resistance and contamination by antibiotic resistance determinants: The two ages in the evolution of resistance to antimicrobials. Front. Microbiol. 2012, 3, 1. [Google Scholar] [CrossRef] [PubMed]
- Antony, R.; Mahalinganathan, K.; Thamban, M.; Nair, S. Organic carbon in Antarctic snow: Spatial trends and possible sources. Environ. Sci. Technol. 2011, 45, 9944–9950. [Google Scholar] [CrossRef] [PubMed]
- Amato, P.; Hennebelle, R.; Magand, O.; Sancelme, M.; Delort, A.M.; Barbante, C. Bacterial characterization of the snow cover at Spitzberg, Svalbard. FEMS Microbiol. Ecol. 2007, 59, 255–264. [Google Scholar] [CrossRef]
- Antony, R.; Krishnan, K.P.; Laluraj, C.M.; Thamban, M.; Dhakephalkar, P.K.; Engineer, A.S. Diversity and physiology of culturable bacteria associated with a coastal Antarctic ice core. Microbiol. Res. 2012, 167, 372–380. [Google Scholar] [CrossRef] [PubMed]
- Bjelic, S.; Brandsdal, B.O.; Aqvist, J. Cold adaptation of enzyme reaction rates. Biochemistry 2008, 47, 10049–10057. [Google Scholar] [CrossRef]
- D’Amico, S.; Claverie, P.; Collins, T.; Georlette, D. Molecular basis of cold adaptation. Philos. Trans. R. Soc. Lond. B Biol. Sci. 2002, 357, 917–925. [Google Scholar] [CrossRef]
- Holding, A.J. The Microflora of Tundra/Tundra Ecosystems: A Comparative Analysis; Cambridge University Press: Cambridge, UK, 1981; pp. 561–585. [Google Scholar]

Publisher’s Note: MDPI stays neutral with regard to jurisdictional claims in published maps and institutional affiliations. |
© 2022 by the authors. Licensee MDPI, Basel, Switzerland. This article is an open access article distributed under the terms and conditions of the Creative Commons Attribution (CC BY) license (https://creativecommons.org/licenses/by/4.0/).
Share and Cite
Dhume, G.M.; Tsuji, M.; Singh, S.M. Identification of Fungal Communities Isolated from Himalayan Glacier Cryoconites. Sustainability 2022, 14, 14814. https://doi.org/10.3390/su142214814
Dhume GM, Tsuji M, Singh SM. Identification of Fungal Communities Isolated from Himalayan Glacier Cryoconites. Sustainability. 2022; 14(22):14814. https://doi.org/10.3390/su142214814
Chicago/Turabian StyleDhume, Gandhali M., Masaharu Tsuji, and Shiv Mohan Singh. 2022. "Identification of Fungal Communities Isolated from Himalayan Glacier Cryoconites" Sustainability 14, no. 22: 14814. https://doi.org/10.3390/su142214814
APA StyleDhume, G. M., Tsuji, M., & Singh, S. M. (2022). Identification of Fungal Communities Isolated from Himalayan Glacier Cryoconites. Sustainability, 14(22), 14814. https://doi.org/10.3390/su142214814

